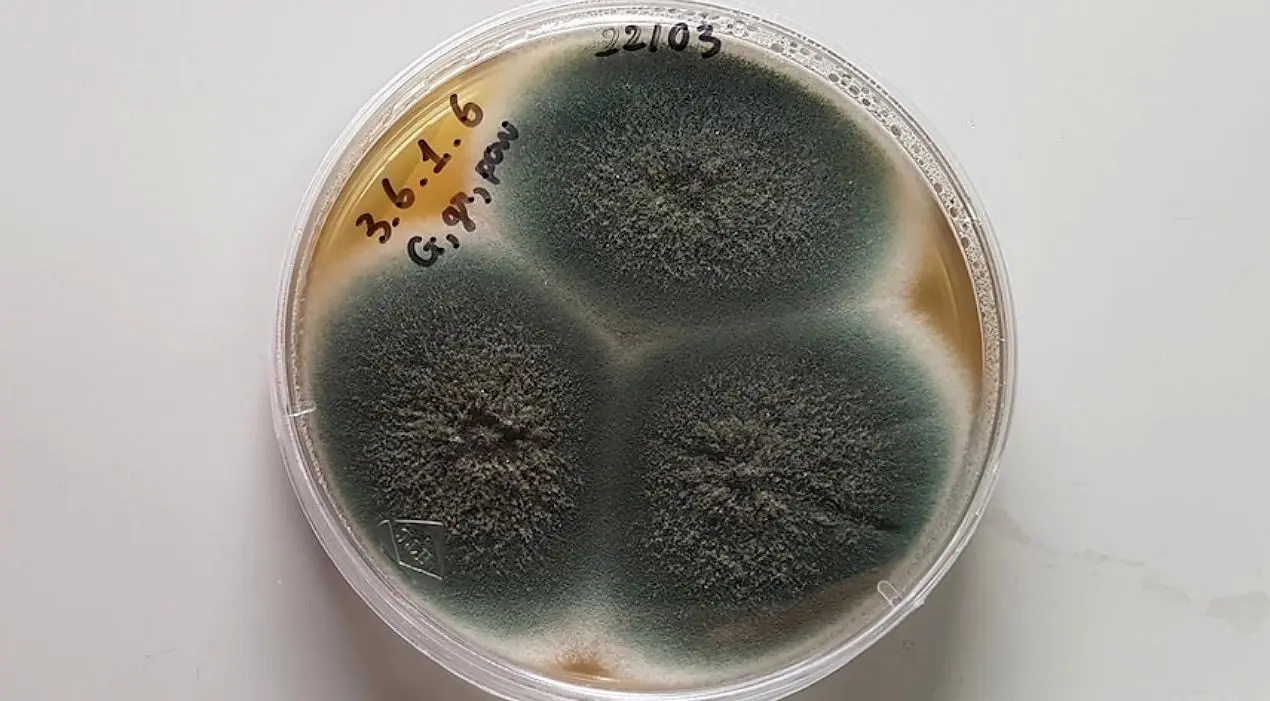
هشدار درباره یک بیماری‌ خطرناک فراموش‌شده

نتایج جستجو :
-
این خوراکی خوشمزه پوست شما را سالم و شاداب میکند
برای داشتن پوستی سالم و شاداب قارچ بخورید. مصرف به اندازه قارچ خواص گوناگونی دارد و بخشی از فواید این خوراکی برای پوست…
-
فروش قارچ ۱۵ میلیونی در نیاوران + عکس
گزارش کاربران در شبکه های اجتماعی از فروش نوعی قارچ در ایران به قیمت هر کیلو ۱۵ میلیون تومان حکایت دارد.
-
هشدار؛ این قارچها را نخورید
مسمومیت با قارچ وحشی امسال سه برابر بیشتر شده و سازمان اورژانس کشور نسبت به پرهیز از مصرف قارچ در طبیعت هشدار میدهد. …
-
بخاطر این ۶ دلیل زیاد قارچ بخورید!
شاید از دور به قارچها نخورد اما آنها بسیار مقوی و منبع ویتامینهای مهمی هستند بنابراین اگر مصرف این گیاه را بیشتر…
-
خبر خوش برای کسانی که قارچ دوست دارند
قارچ یکی از بهترین مواد غذایی برای تامین سلامت بدن است. یکی از مهمترین فواید قارچ را که طی تحقیقی کشف شده، در این خبر…
-
این ماده غذایی تا ۶ ماه آینده گران نمیشود
قیمت قارچ در راستای شعار سال حداقل تا ۶ ما آینده افزایش قیمتی ندارد.
-
هشدار؛ این مواد غذایی را نباید قبل از پختن بشویید
شستن برخی مواد خوراکی پیش از اینکه پخته شود بسیار خطرناک است.
-
ترسناکترین قارچ دنیا که شبیه زامبی است را ببینید!+عکس
گاهی زیبا و دلنشین، گاهی زشت و ترسناک، برخی موجودات شباهتی انکارناپذیر به اجسام و موجودات دیگر دارند.
-
هشدار درباره یک بیماری خطرناک فراموششده
هشدار مهم به دلیل عدم تمرکز تاریخی به این معنی است که شکافهای بزرگی در دانش و همچنین کمبود نظارت، درمان و تشخیص وجود د…
-
قیمت قارچ سر به فلک کشید/ صادرات دو برابری به روسیه
قیمت کنونی هر کیلو قارچ سرمزرعه را ۵۰ تا ۶۰ هزارتومان و خرده فروشیها ۷۰ تا ۷۵ هزار تومان است. با بهبود عرضه، قیمت طی…